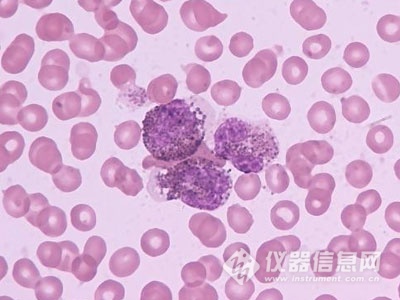

據巴西媒體報道,巴西科研人員最近利用納米生物復合材料研制出一種新型電子設備,可以像測血糖一樣快速診斷白血病,為挽救患者生命爭取時間。據介紹,這種新設備可在一個小時之內檢測出患者是否攜帶癌細胞,而現行的診斷方法最長要三個星期才能有結果。鑒于某些白血病的癌細胞擴展速度極快,快速確診有著重要意義。
巴西圣保羅大學等機構的研究人員報告說,他們將納米金粒子與一種稱為菠蘿蜜凝集素的物質結合,并加入熒光染料,制成納米生物復合材料傳感器,以此為基礎研制出新的檢測設備。
菠蘿蜜凝集素是一種從菠蘿蜜中提取的蛋白質,能夠識別人體癌細胞里大量存在的特定糖類物質,進而確認癌細胞的存在。如果血液樣本中存在癌細胞,與傳感器發生相互作用后,就會發出熒光。研究人員說,這種方法類似于通過血液檢測測量血糖值。
除了所需時間短,新設備還有低成本、便攜等優點,有利于診所推廣使用。研究團隊計劃在更大范圍的病人中進行臨床試驗,進一步證實其效果并尋求實用化,預期該產品有可能在兩年內投放市場。